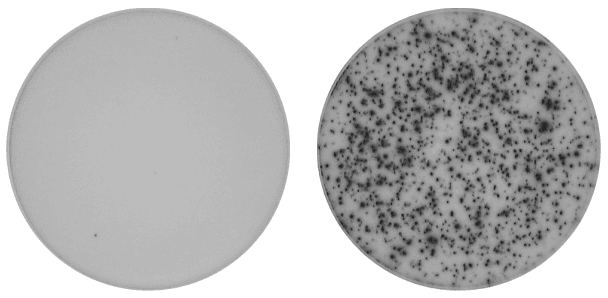

If one cell responds, you will find it
ELISpot is a robust and straightforward assay for detecting and quantifying antigen-specific immune responses at the single-cell level. For almost 40 years, researchers have trusted Mabtech’s ELISpot kits for their reliability and high sensitivity in capturing both T cell and B cell responses. So how does ELISpot work? Well, similarly to ELISA, but instead of measuring an analyte in solution, ELISpot detects the cells secreting that analyte. Please have a look at the video below!
Confidence in every well
We know your samples are precious and your results must be trusted. That’s why we pair proven assay technology with direct access to experienced support scientists. If something doesn’t go as planned, we’ll work with you to get it right. Because our goal isn’t just an assay that runs, it’s an assay that delivers trustworthy results, every single time.
ELISpot you can trust
ELISpot from Mabtech means quality through and through. You’re getting more than a kit, you’re getting years of assay innovation, optimized protocols, and the tools you need to generate data you can trust to drive your research and therapies forward.
Decades of expertise: 40 years dedicated to advancing ELISpot technology, with trusted antibodies and kits used in thousands of peer-reviewed studies and clinical trials.
Exceptional sensitivity: Detects even the rarest antigen-specific T and B cells, ensuring no important response goes undetected.
In-house antibody development: Proprietary monoclonal antibodies give unmatched specificity and affinity, batch after batch.
Integrated reading solutions: Mabtech ASTOR™ 2 and Mabtech IRIS™ 2 readers with the patented RAWspot™ algorithm provide the highest precision in spot detection and counting available.
T cell applications
ELISpot is commonly used to investigate antigen-specific immune responses and to discriminate between subsets of activated T cells. This is applied in studies of infectious diseases, cancer, allergies, and autoimmune diseases. In vaccine research, IFN-γ ELISpot is the gold standard to define vaccine efficacy by measuring the capacity to elicit potent T cell responses. Diagnostic assays based on ELISpot are also readily available, including tests to detect patients with tuberculosis or SARS-CoV-2 infection by measuring IFN-γ secretion from T cells responding to defined antigens. And please note: ELISpot is not limited to IFN-γ. We offer ELISpot in over 40 different cytokines and other analytes to answer all your research questions.
Immunotherapy
ELISpot is a powerful potency assay in CAR-T, TIL, and gene therapy development, giving clear insight into cytokine release such as IFN-γ, Granzyme B, and TNF-α from engineered T cells or virally transduced cells. These assays align with FDA recommendations for immunotherapy potency testing.
Infectious disease
Vaccines
B cell applications
B cell ELISpot is one of few assays that can measure immunoglobulins directly upon secretion. One can assess total immunoglobulin secretion by antibody-secreting cells (ASCs) or memory B cells, as well as antigen-specific B cell responses from both cell types using the antigen of interest as a capture or detection reagent.
Detect acute or memory B cell responses
B cell ELISpot can be used to answer several research questions in infection and vaccine research. One can assess early acute ASC responses following vaccination or during infection by isolating the cells directly from donor blood and using them in the assay. Additionally, researchers can assess the memory B cell response elicited by a vaccine or following infection to assess the longevity of the B cell response. Here, isolated PBMCs are stimulated with polyclonal activators to induce memory B cells to secrete antibodies for assessment in the assay.
ELISpot kit formats
ELISpot Flex
Adaptable
Our most flexible ELISpot kit option available when you already have plates and ELISpot substrate.
Total assay time:
- 3-day protocol
- 2-step detection
Kit size options:
- Reagents for 4 plates
- Bulk options available upon request
ELISpot Plus
Reproducible
Our most popular ELISpot kits with everything you need for the assay including a positive control (for human and NHP kits).
Total assay time:
- 2-day protocol
- 2-step detection
Kit size options:
- 2- or 10-plate kits
- 100-plate kits for certain analytes
- Bulk options available upon request
ELISpot Pro
One-step detection
The benefits of the Plus format, but with a one-step detection system. Ideal when time is of the essence!
Total assay time:
- 2-day protocol
- 1-step detection
Kit size options:
- 2- or 10-plate kits
- 100-plate kits for certain analytes
- Bulk options available upon request
ELISpot Path
Antigen-specific
A complete ELISpot kit to answer your specific scientific question with an included PepPool and positive control. Just add cells!
Total assay time:
- 2-day protocol
- 1- or 2-step detection
Kit size options:
- 1-plate kit
- Bulk options available upon request
Want to explore more?